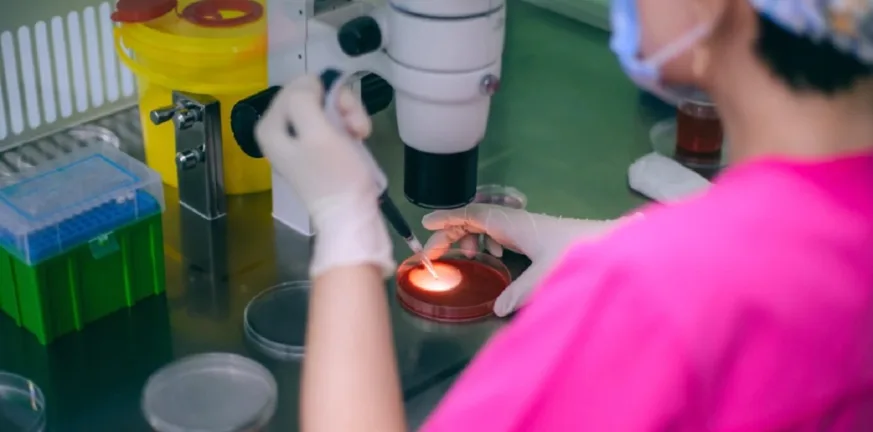
197 παιδιά σε όλη την Ευρώπη από δότη σπέρματος με καρκινογόνα μετάλλαξη – Ανάμεσά τους και στην Ελλάδα

197 παιδιά σε όλη την Ευρώπη από δότη σπέρματος με καρκινογόνα μετάλλαξη – Ανάμεσά τους και στην Ελλάδα
Σοκ προκαλεί μεγάλη ευρωπαϊκή έρευνα που αποκαλύπτει ότι ανώνυμος δότης σπέρματος με σπάνια γενετική μετάλλαξη συνδέεται με εκατοντάδες γεννήσεις και αυξημένο κίνδυνο καρκίνου. Το σπέρμα του χρησιμοποιήθηκε και στην Ελλάδα, ενώ ήδη έχουν καταγραφεί ασθένειες και θάνατοι.
Τουλάχιστον 197 παιδιά σε 14 ευρωπαϊκές χώρες, ανάμεσά τους και στην Ελλάδα, γεννήθηκαν από ανώνυμο δότη σπέρματος που, εν αγνοία του, έφερε σπάνια γενετική μετάλλαξη η οποία αυξάνει δραματικά τον κίνδυνο εμφάνισης καρκίνου. Κάποια από τα παιδιά έχουν ήδη χάσει τη ζωή τους, ενώ όσα έχουν κληρονομήσει τη μετάλλαξη ζουν με σχεδόν βέβαιη την πιθανότητα εκδήλωσης της νόσου.
Η αποκάλυψη προέρχεται από μεγάλη διασυνοριακή δημοσιογραφική έρευνα 14 δημόσιων ραδιοτηλεοπτικών οργανισμών της Ευρώπης, ανάμεσά τους και το BBC, στο πλαίσιο του Δικτύου Ερευνητικής Δημοσιογραφίας της Ευρωπαϊκής Ραδιοτηλεοπτικής Ένωσης (EBU).
Η μετάλλαξη και το σύνδρομο Li-Fraumeni
Ο άνδρας ξεκίνησε να δωρίζει σπέρμα το 2005, ως φοιτητής, και συνέχισε επί περίπου 17 χρόνια. Θεωρούνταν υγιής και είχε περάσει όλους τους προβλεπόμενους ιατρικούς ελέγχους. Ωστόσο, μέρος του γενετικού του υλικού έφερε μετάλλαξη στο γονίδιο TP53, το οποίο είναι ζωτικής σημασίας για την καταστολή της ανάπτυξης καρκινικών κυττάρων.
Η μετάλλαξη εντοπιζόταν μόνο σε ποσοστό έως 20% του σπέρματός του. Όταν όμως ένα παιδί συλλαμβάνεται από αυτό το σπέρμα, η μετάλλαξη υπάρχει σε όλα τα κύτταρα του οργανισμού του. Πρόκειται για το σύνδρομο Li-Fraumeni, το οποίο συνδέεται με έως και 90% πιθανότητα εμφάνισης καρκίνου κατά τη διάρκεια της ζωής, συχνά από την παιδική ηλικία, αλλά και με αυξημένο κίνδυνο καρκίνου του μαστού σε γυναίκες αργότερα.
«Είναι μια τρομακτική διάγνωση», δήλωσε στο BBC η καθηγήτρια γενετικής καρκίνου Clare Turnbull από το Ινστιτούτο Έρευνας Καρκίνου του Λονδίνου. «Πρόκειται για ένα βάρος που συνοδεύει μια οικογένεια σε όλη της τη ζωή. Είναι πραγματικά καταστροφικό».
Συνεχής ιατρική επιτήρηση και προληπτικές επεμβάσεις
Τα παιδιά που φέρουν τη μετάλλαξη υποβάλλονται σε ετήσιες μαγνητικές τομογραφίες σώματος και εγκεφάλου, καθώς και σε υπερηχογραφήματα κοιλίας. Πολλές γυναίκες, υπό τον φόβο της νόσου, επιλέγουν ακόμη και προληπτική μαστεκτομή, ώστε να μειώσουν τον κίνδυνο.
Γιατροί που παρακολουθούσαν παιδιά με καρκίνο συνδεδεμένο με δωρεές σπέρματος έκρουσαν φέτος τον κώδωνα του κινδύνου στο Ευρωπαϊκό Συνέδριο Ανθρώπινης Γενετικής. Από τα αρχικά 67 παιδιά που είχαν εντοπιστεί, τα 23 έφεραν τη μετάλλαξη, ενώ τα 10 είχαν ήδη διαγνωστεί με καρκίνο.
Μετά από αιτήματα πρόσβασης σε δημόσια έγγραφα και συνεντεύξεις με γιατρούς και οικογένειες, η έρευνα αποκάλυψε ότι ο πραγματικός αριθμός των παιδιών που έχουν γεννηθεί από τον ίδιο δότη είναι τουλάχιστον 197, ενώ σε αρκετές χώρες δεν έχουν ακόμη ολοκληρωθεί οι καταγραφές.
«Δεν έχω θυμό, αλλά είναι απαράδεκτο»
Η Céline (το όνομα είναι ψευδώνυμο), από τη Γαλλία, απέκτησε παιδί με το σπέρμα του δότη πριν από 14 χρόνια. Η κόρη της φέρει τη μετάλλαξη. Όπως λέει, ενημερώθηκε με τηλεφώνημα από την κλινική γονιμότητας στο Βέλγιο:
«Δεν έχω απολύτως κανένα αρνητικό συναίσθημα για τον δότη. Όμως είναι απαράδεκτο να μου δοθεί σπέρμα που δεν ήταν ασφαλές και περιείχε τόσο σοβαρό κίνδυνο».
Ξέρει ότι ο καρκίνος θα αποτελεί μόνιμη απειλή για το παιδί της:
«Δεν ξέρουμε πότε, δεν ξέρουμε ποιος, δεν ξέρουμε πόσοι. Αν συμβεί, θα παλέψουμε. Αν συμβεί ξανά, θα παλέψουμε ξανά».
Το σπέρμα χρησιμοποιήθηκε και στην Ελλάδα – Κενό στη διεθνή νομοθεσία
Το σπέρμα του συγκεκριμένου δότη χρησιμοποιήθηκε από 67 κλινικές γονιμότητας σε 14 χώρες, μεταξύ των οποίων:
Δανία, Βέλγιο, Ισπανία, Ισλανδία, Γερμανία, Ελλάδα, Κύπρος, Βόρεια Μακεδονία, Γεωργία, Ουγγαρία, Ιρλανδία, Πολωνία, Αλβανία και Σερβία.
Δεν υπάρχει ενιαίο διεθνές νομικό πλαίσιο που να περιορίζει πόσες φορές μπορεί να χρησιμοποιηθεί το σπέρμα ενός δότη παγκοσμίως. Κάθε χώρα θέτει διαφορετικά όρια. Στο Βέλγιο, για παράδειγμα, ένας δότης επιτρέπεται να χρησιμοποιείται από έως έξι οικογένειες. Στην πράξη όμως, 38 γυναίκες απέκτησαν 53 παιδιά από το σπέρμα του ίδιου άνδρα. Στο Ηνωμένο Βασίλειο, το όριο είναι 10 οικογένειες ανά δότη.
Η Ευρωπαϊκή Τράπεζα Σπέρματος παραδέχθηκε ότι τα όρια «δυστυχώς παραβιάστηκαν» σε ορισμένες χώρες και ότι βρίσκεται πλέον σε διάλογο με τις αρμόδιες αρχές στη Δανία και το Βέλγιο.
Η «Πελοπόννησος» και το pelop.gr σε ανοιχτή γραμμή με τον Πολίτη
Η φωνή σου έχει δύναμη – στείλε παράπονα, καταγγελίες ή ιδέες για τη γειτονιά σου.
Ακολουθήστε μας για όλες τις ειδήσεις στο Bing News και το Google News





